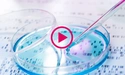
Dyoung webinar biotech5

Webinars and Videos
European biotech patent case law

Patent newsletter
Latest edition

Patent Book
EPO Board of Appeal Decisions